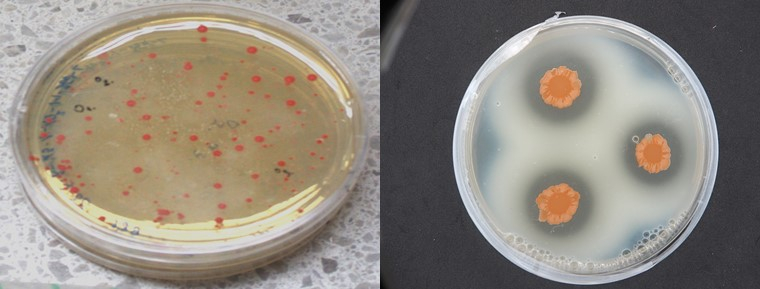

Panel 1 (Research Day 2023)
Panel Chair | Elisabeth Priedl
09.45 | Fragmented Memories: Leisure and Defence on the Adriatic Coast*
Anamarija Batista
10.30 | MTLS – Preliminary Data*
Ursula Mayer, Attilia Fattori Franchini
11.15 | Pretty in Pink? New Restoration Treatments to Mitigate Salt Crystallizations and Pink Discoloration in Historic Buildings
Guadalupe Piñar, Beate Sipek
Presentations of Artistic Research projects are highlighted with a *.
Fragmented Memories: Leisure and Defence on the Adriatic Coast | Anamarija Batista*
During the period defined as ›modernism‹, the Adriatic coast of the Socialist Federal Republic of Yugoslavia underwent a massive transformation. The rise of (mass) tourism exerted a particular impact, which has characterized the region to this day. It is less known that in the same period, the most important defence lines of the country were established in this area.
The idea of unproductive time, of vacations dedicated to rest and relaxation, meets the idea of strategic military planning for the future. Putting the two ›concepts‹ side by side and thinking about their spatial and temporal structures, a certain paradox emerges. Today's transformations seem to reverse this paradox. While the former military areas are freely accessible, the tourism infrastructure is rapidly being transformed and they are falling prey to the idea of exclusivity for their own guests. The former mixture and ›sharing‹ of the infrastructure with the local population seems to vanish. Also the idea that these areas could be put to a different use is struggling to take hold.
What utopian, collective ideas moved the Yugoslav society? How has this perspective changed and how do current developments lead to new/old forms of inequality and ›consumerist elitism‹?
about the project
Fragmented Memories: Leisure and Defence on the Adriatic Coast
Institute for Art Theory and Cultural Studies | FWF Top Citizen Science (TCS114), 05/2022 – 04/2024
Emir Kulačić (Sound), Mirela Lambić (Actor), Olaf Osten (Drawings) Arthur Summereder (Cut & Camera), Goran Škofić (Camera)
The art-based research project ›Adriatic Coast as a Leisure and Defence Paradise‹ examines the phenomena of military and tourist urbanisation as well as their impact on the Adriatic coast and the life of the local population. Through interviews, archive research, film, collages and especially developed and repeatedly redrawn mappings, it aims to intersect the past and the present as well as official information and individual stories. Six tourist-military sites were carefully selected as case studies.
Weblink
https://leisureanddefence.org/en
Project partner
Antonia Dika (The University of Arts Linz)
MTLS – Preliminary Data | Ursula Mayer, Attilia Fattori Franchini*
In this presentation, we share our interim research findings resulting from extensive collaborations with a diverse range of practitioners, including artists, scientific researchers, science-fiction writers, poets, and critical theorists. Our primary focus is to explore the creative potentials that emerge from the dynamic interaction between artificial intelligence (AI) and non-human entities. We investigate how speculative fiction and feminist fabulation can contribute to the development of a generative methodology that gives rise to alternative lifeworlds.
To facilitate this collaborative endeavor, we have developed mtls.world, a digital ecosystem specially designed to foster interdisciplinary cooperation. Throughout the presentation, we will provide a glimpse into the mtls.world digital platform, highlighting how it was conceived as an ecosystem, its development and our work in progress — the main repository for our project. MTLS – digital platform serves as an interactive space for thoughtful exchange and collective reflection among project participants and interested parties alike.
about the project
MTLS – Mythopoesis for Techno Living Systems
Institute for Art Theory and Cultural Studies | FWF PEEK (AR658),
06/2021 – 05/2024
Attilia Fattori Franchini, Rachel Claire Hill
What are the creative potentials emerging through collaboration and interplay between AI and non-human entities? ›Mythopoesis for Techno Living Systems‹, delves into the liberating potential of myth-making and speculative thinking by merging technoscientific research with artistic practice. It asks questions such as whether the practices of speculative fiction and feminist fabulation can serve as methodologies for incorporating non-human entities into the creation of alternative knowledge. Moreover, it explores how digital technologies such as AI enable us to challenge and redefine our perception of what it means to be ›human‹.
To achieve this, we have initiated collaboration among a diverse range of practitioners, including artists, scientific researchers, science-fiction writers, poets, and critical theorists through what we term ›writing speculative collectivities‹ — all of which serves as a generative methodology producing alternative epistemologies. The unique digital platform mtls.world, conceived as a generative virtual ecosystem, is the primary repository of the project, fostering meaningful exchanges and collective reflections as open-ended and experimental processes.
Weblink
https://mtls.world
Pretty in Pink? New Restoration Treatments to Mitigate Salt Crystallizations and Pink Discoloration in Historic Buildings | Guadalupe Piñar, Beate Sipek
The presentation shows the restoration work carried out by IKR restorers on two selected buildings displaying salt crystallization. Sustainable desalination treatments have been carried out by applying new mineral poultices on the walls, and long-term monitoring has been carried out.
We also show the biological analyses carried out in the INTK laboratories to study the microbial communities present in the buildings using state-of-the-art molecular methods, as well as classical microbiology. Tests are also being carried out on mock-ups inoculated with selected microbes in a climatic chamber to simulate crystallization cycles and to see the adaptation mechanisms of these microorganisms.
about the project
Pretty in Pink? New Restoration Treatments to Mitigate Salt Crystallizations and Pink Discoloration in Historic Buildings and Monitoring of their Effectiveness through ›Omics‹ Analysis
Institute for Natural Sciences and Technology in the Arts + Institute for Conservation - Restauration | ÖAW Heritage Science Austria, 10/2021 – 09/2025
Guadalupe Piñar, Beate Sipek
Johannes Tichy, Martin Ortbauer
This project focuses on how climate change will increase the number of salt crystallization cycles in historic buildings. Salt crystallization occurs on architectural surfaces under changing environmental conditions and the pressure exerted by the salt is responsible for the damage caused. In addition, salt crystallizations in buildings mimic saline environments by providing an ecological niche for halophilic (salt-loving) microorganisms, which contain carotenoid pigments that produce additional aesthetic damage consisting of pinkish patinas.
The objective is to investigate the effect of salt crystallization cycles in building materials and how they affect microbial communities and their biological activity. For this purpose, two historic buildings displaying salt crystallizations have been selected. The conservator-restorers are controlling the microclimatic parameters and performing a sustainable desalination treatment on both buildings by applying new mineral poultices on the walls, and doing a long-term monitoring. Biologists are studying the microbial communities present in the buildings through state-of-the-art molecular methods (NGS- and Third-Generation Sequencing technologies) as well as classical microbiology. Tests are also being carried out with mock-ups inoculated with selected microbes in a climate chamber to simulate crystallization cycles to see the adaptation mechanisms of these microorganisms. The implementation of this project requires a coordinated interdisciplinary consortium of expertise spanning microbiology, bioinformatics (for data analyses) and conservation-restoration.
Project partners
Alexandra Graf (Applied Life Sciences/Bioengineering/Bioinformatics), Monika Waldherr, Lukas Fürnwein (all FH Campus Vienna)